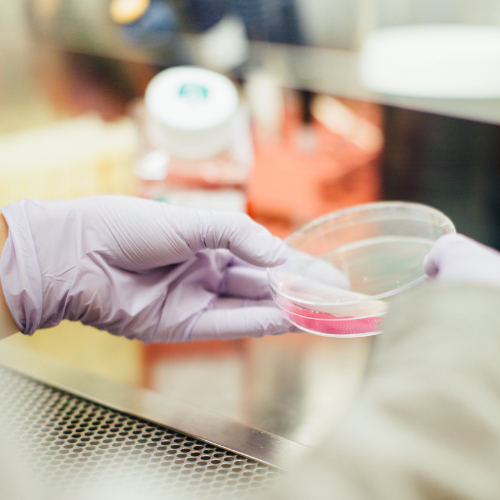

Free Printable Dual Science Center – Science center this science center sign can be placed in the part of the classroom dedicated to experiments and research. Browse science center printable display resources on teachers pay teachers, a marketplace trusted by millions of teachers for original educational resources. Then, dig deeper by exploring more facts about dolphins, seahorses, and even lobsters. Don't plan your lesson alone.
Ct Science Center Woodruff Brown
Free Printable Dual Science Center
The six steps of the scientific method include: Everything you need to teach kids science all in one place! Then they go to “live” in the science center.
Sign Up And Get 10% Off Books!
Unique drawings that help students understand science concepts, ngss and teks aligned. Free science worksheets & printables. These free offline activities can.
As The Science Materials Are Introduced To The Children;
Children participate in making observations, experimenting, and drawing conclusions. Simply print and go.these activities will help your students practice the phonics patterns you’re teaching them.perfect for centers, homework, morning work, and more.printable. No prep, just print and go.
The Key To Keeping Any Center In Your Classroom Neat Is To Have.
Ad bring learning to life with worksheets, games, lessons, & more for every grade & subject. Science center sign {american spelling} use these colorful science center signs to help kids visualize the predefined science area in your classroom. Award winning educational materials designed.
Download Free Pdf Version Download Free.
Science resources, packets, assessments, and more. Students can learn science everyday! Use our free science worksheets, coloring pages, and other printables to make science come alive in your classroom!
Science Printables For All Ages Increase Your Child's Interest In Investigating, Exploring, And Experimenting With These Free Printable Activities.
Indeed, science is all around us, so use it to expand your child’s knowledge and interest.

Science Center Set Up and Ideas for Preschool
How to set up the Science Center in your Early Childhood Classroom

Free Printable High School Space Science Worksheet Time4Learning

How to set up the Science Center in your Early Childhood Classroom

How to set up the Science Center in your Early Childhood Classroom

Science Coloring Pages For Kids at Free printable

CT Science Center Woodruff Brown

How to set up the Science Center in your Early Childhood Classroom

Free Printable Center Signs For Pre K Free Printable

Free Printable High School Space Science Worksheet Time4Learning

FREE Earth Science Unit Study (50+ activities & Printables) Free

dual Allgemein

Free Science Pictures Cliparts.co

How To Set Up Preschool Science Centers and Discovery Tables
GCSE Dual Science Award Exam